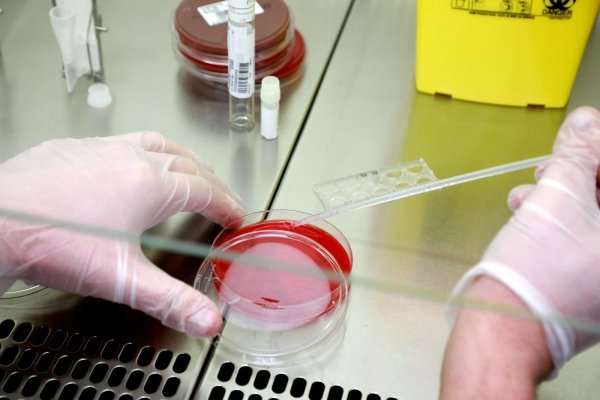

Pathologen-Verbände und das Robert-Koch-Institut betonen, dass innere Leichenschauen wertvolle Erkenntnisse im Kampf gegen das Virus liefern können. In OWL wurde jedoch bislang kein Leichnam obduziert.
Warum in OWL keine Corona-Toten obduziert werden